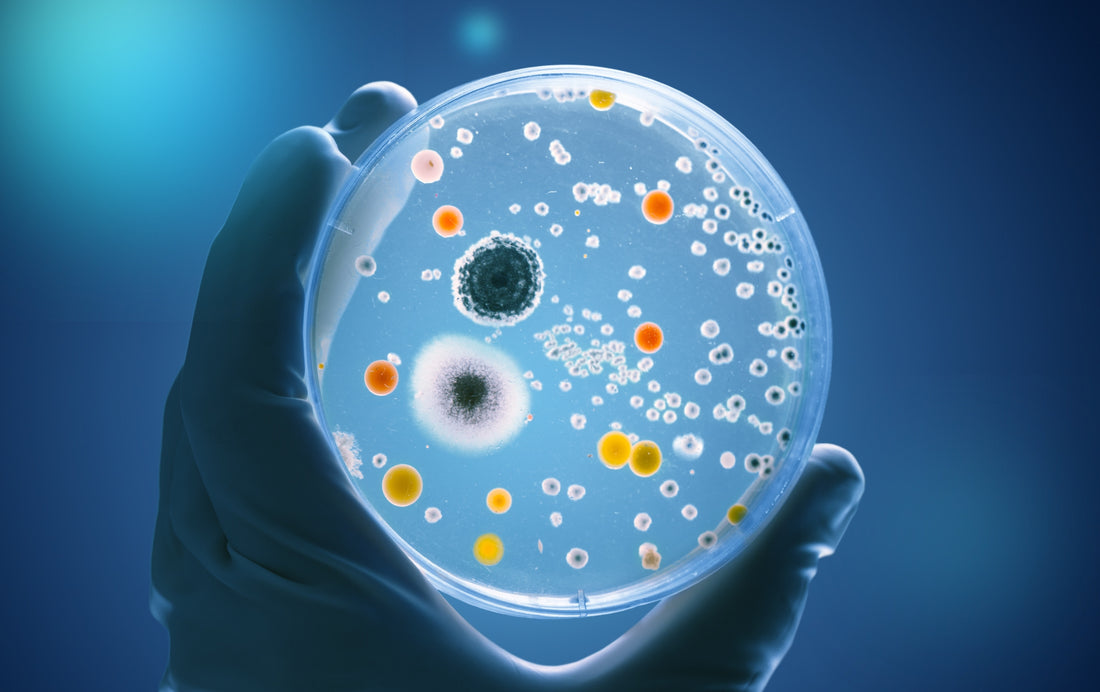

Mitochondria and Your Microbiome
Share
Mitochondria: The Master Communicators of Your Microbiome
For a long time, we've assumed that mitochondria and the microbiome are two entirely separate entities. Why should we think otherwise?
Mitochondria are organelles central to the function of the cell. The microbiome is, well, microbes: a community of microorganisms that we now understand work together to play an essential role in digestion and absorption, vitamin production, immune regulation, metabolic and neurological health, and much more. Until now, these two entities have been seen as important but not directly related.
Recent research indicates, however, that the mitochondria and your microflora are in a perpetual, intricate relationship. This relationship turns out to be pivotal in understanding the pathophysiology of many common diseases - from Parkinson's disease and autism to obesity and Type 2 diabetes to many kinds of cancer. More importantly, understanding this connection may well be critical in the prevention and recovery of these conditions. Indeed, it was already well known that dysregulated mitochondria and a dysbiotic microbiome were found in
each of these diseases - but new discoveries are revealing the ways they are linked and influence one another.
While we know that each entity exerts substantial impact on host wellbeing and resilience, it was not until recently that we fully understood how microbes have such a powerful impact on whole body and brain health. Now, it's becoming more and more clear that the microbiome acts through the mitochondria.
Meet your Mitochondria
Most people think of mitochondria as the "energy maker of the cell" and while this is still true, the mitochondria are quite a bit more complex and evolved than that. Each mitochondrion is unique and manifests different biochemical and structural qualities depending on their role particular host cells and organs. Mitochondria in all various forms can coexist in the same cell and are referred to as the "mitobiota".
Within the cell, mitochondria coordinate vital metabolic functions - from fatty acid oxidation and oxidative phosphorylation to carrying out ATP production to generate the energy that drives all cellular functions. Through these metabolic functions, your mitochondria also play a signaling role in the control of nuclear activities. Mitochondria actively modulate gene expression in the nucleus by way of alpha‐ketoglutarate metabolites, reactive oxygen species (ROS), and mitochondrial unfolded protein responses (UPR).
Your mitochondria guide the immune response as well. When damaged, mitochondria produce and release alarmins (also known as DAMPS), which are pro-inflammatory and initiate profound innate and adaptive immune responses both locally and systemically. Clinically speaking, the mitochondria determine temperature control; fat metabolism; inflammation and autoimmunity; energy, stamina, and fatigue; high-level brain function and activity, and more.
Making Sense of the Mitochondria-Microbiome Connection
We've known for some time that the body's microbiome is a route through which microscopic organisms and the outside world influence what is happening in our inner world. One way this happens is through microbiome composition, diversity, and stability. Ongoing research shows that the microbial makeup differs between people who have physical and mental health disorders - including multiple sclerosis, Parkinson's disease, autism, schizophrenia, depression, anxiety, obesity, inflammatory bowel disease, and Type 2 diabetes - as compared to those who don't have those conditions.
But what is the mechanism by which the micro-organisms had such profound influence within the inner sanctum of our bodies? Ground-breaking research has revealed that the microbiome targets your mitochondria in numerous ways - in part through quorum sensing mechanisms, a way bacteria communicate with one another - and in doing so, profoundly impacts cellular and organ function.
By way of this relationship, the microbiome can contribute to host energy production through synthesis of chemicals like bile acids, pyrroloquinoline, quinone, and fermentation gases that shift mitochondrial function. Healthy, balanced microbiota can promote the insertion of mtDNA (mitochondrial DNA) into nuclear DNA sequences that alter mitochondrial and, therefore, cellular behavior. Your microflora also produces metabolites that alter mitochondrial activity. These metabolites include short-chain fatty acids, which can activate AMP kinase and increase new mitochondria or pro-inflammatory ROS (reactive oxygen species) production.
In turn, the mitochondria affect the function of the microbiome. For example, we know that high diversity of microbes in the body is key to robust health. Recent research suggests that mitochondrial DNA plays an essential role in species diversity of the gut microbiome. Further, mitochondria produce increased reactive oxygen species, which also can alter gut microbiome diversity. This influence goes both ways. Ultimately, recent research has shown, again and again, how truly interconnected these aspects of your health are.
The microbiome has a direct line of communication with mitochondria, which play a pivotal role in cell and organ function. Cell and organ function influences the brain, body, and behavior. Mitochondria respond to what is happening in the body by directly influencing the stability, diversity, and overall makeup of the microbiome. There is no doubt that there is much more to be revealed about this fundamental relationship between the gut microbiome and mitochondrial resilience.

Dr. Maya Shetreat, MD
Neurologist, Herbalist, Urban Farmer, and Author of The Dirt Cure
A neurologist, herbalist, urban farmer, and author, Dr. Shetreat has been featured in the New York Times, The Dr. Oz Show, NPR, The Telegraph, Sky News, and more. Dr. Maya teaches Terrain Medicine™, earth-based programs for transformational healing at the Terrain Institute, which she co-founded. A lifelong student of ethnobotany, plant healing, and the sacred, Dr. Maya works and studies with indigenous communities and healers from around the world.
Collective members are paid sponsors and receive compensation for their content, but all opinions are their own.